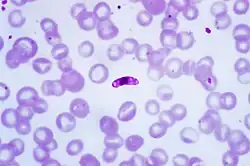

Parasitémie
La parasitémie est la quantité d'un parasite présent dans le sang humain ou animal (plasmodium falciparum ou autre plasmodium paludique, dans le cas du paludisme par exemple)
Elle est utilisée pour le diagnostic d'une maladie parasitaire, ou l'efficacité du traitement contre cette maladie.
La non efficacité du traitement peut faire évoquer une antibiorésistance
Notes et références
Références
Bibliographie
Voir aussi
Articles connexes
Liens externes
- Portail de la médecine